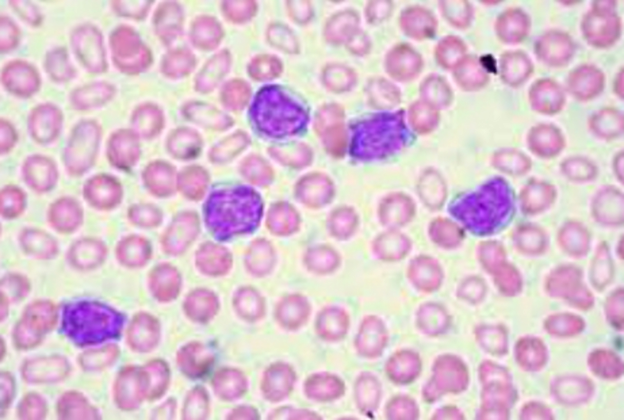

Imunoterapija
T-limfociti iskorijenili leukemiju kod dvoje djece
Znanstvenici vjeruju kako bi se imunološki pristup liječenju mogao razviti u tretmane za mnoge tipove raka.
Nakon novog tretmana staničnom terapijom koja je reprogramirala imunološke stanice da se ubrzano umnožavaju i uništavaju stanice leukemije, dvoje djece s agresivnim oblikom leukemije doživjelo je potpunu odsutnost aktivnosti bolesti, bez ikakvih dokaza o postojanju stanica raka u njihovim tijelima.
Istraživački tim iz Dječje bolnice Philadelphia i sa Sveučilišta u Pennsylvaniji objavio je ovo izvješće o dva pedijatrijska pacijenta online u časopisu The New England Journal of Medicine.
U prosincu 2012. godine kod jedne od pacijentica, sedmogodišnje djevojčice Emily Whitehead, nakon pokusne terapije došlo je do njezina dramatičnog oporavka, nakon što joj se stanje pogoršalo od konvencionalnog liječenja. Emily je ostala zdrava i 11 mjeseci nakon primanja bioinženjerskih T-limfocita koji su poništili ovaj tip leukemije, nazvan akutna limfoblastična leukemija (ALL).
Kod druge pacijentice, desetogodišnje djevojčice, koja je također imala potpuni odgovor na isti tretman, nakon dva mjeseca došlo je do povratka bolesti kada su se pojavile druge stanice leukemije koje nisu imale specifični stanični receptor koji je ciljan terapijom.
"Ova studija opisuje kako te stanice imaju snažan protutumorski učinak kod djece", rekao je suautor studije Stephan A. Grupp, doktor medicine i znanosti iz dječje bolnice Philadelphia, gdje su obje pacijentice bile podvrgnute ovom kliničkom ispitivanju. "Međutim, naučili smo da ćemo kod nekih pacijenata s akutnom limfoblastičnom leukemijom morati dodatno izmijeniti tretman, pritom ciljajući i druge molekule na površini stanica leukemije."
Nova studija koristi relativno novi pristup u liječenju raka: imunoterapiju, koja manipulira imunološkim sustavom kako bi povećao svoje sposobnosti u borbi protiv raka. Istraživači su stvorili T limfocite koji selektivno ubijaju drugu vrstu imunoloških stanica, B limfocite, koje su postale kancerogene.
T limfociti su najveći radnici imunološkog sistema. Oni prepoznaju i napadaju bolesne stanice koje ga napadaju. Međutim, stanice raka prođu pored radara imunološkog nadzora, pritom izbjegavajući otkrivanje T limfocitima. Novi pristup prilagođen je tako da dizajnira T limfocite da "vide" i napadnu stanice raka.
Istraživači su uklonili neke od vlastitih T limfocita pacijenata i modificirali ih u laboratoriju kako bi stvorili oblik kimernog antigen receptora (CAR), stanicu nazvanu CTL019. Ove stanice dizajnirane su za napad na protein CD19 koji se nalazi samo na površini određenih B limfocita.
Stvaranjem protutijela koje prepoznaje CD19 i zatim povezivanjem tog protutijela na T limfocite, znanstvenici su u CTL019 stanicama stvorili vrstu vođenog projektila koji se veže na B limfocite i potom ih ubija, tj. napada leukemiju B limfocita. Nakon što se vrate u tijelo pacijenta, CTL019 stanice višestruko se umnožavaju i cirkuliraju tijelom. I što je važno, ostaju mjesecima nakon toga, štiteći od povratka ove specifične vrste leukemije.
Dok CTL019 stanice eliminiraju leukemiju, također mogu izazvati prejaki imunološki odgovor uslijed otpuštanja citokina koji uključuje opasno visoku temperaturu, nizak krvni tlak i druge nuspojave. Ova komplikacija bila je česta kod Emily te su joj liječnici morali osigurati tretmane koji će ju brzo ukloniti oslabljujući prejaki imunološki odgovor, istovremeno pokušavajući sačuvati protuleukemijsku aktivnost modificiranih T limfocita.
Terapija CTL019 eliminira sve B limfocite koje nose CD19 receptor: zdrave stanice, kao i one s leukemijom. Pacijenti mogu živjeti bez B limfocita, iako zahtijevaju redovne infuzije imunoglobulina, koje se mogu primiti i kod kuće kako bi obavljali imunološke funkcije koje inače obavljaju B limfociti.
"Nastanak tumorskih stanica koje više ne sadrže ciljne proteine sugerira da ćemo u određenih pacijenata s visokorizičnom ALL morati proširiti tretman koji uključuje dodatne T limfocite koje mogu napadati dodatne mete", rekao je Groupp. "Međutim, početni rezultati s ovim imunološkim pristupom ohrabrujući su i mogli bi kasnije razviti u tretmane i za druge tipove raka."
Izvor: Znano.st
Učitavam komentare ...